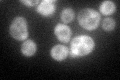
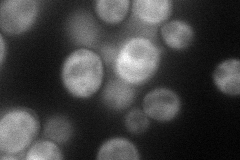
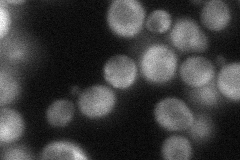
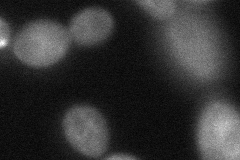

View description
RNA binding protein that sequesters CLN3 mRNA in cytoplasmic foci; cytoplasmic retention factor for Cdc28p and associated cyclins; regulates cell fate and dose-dependently regulates the critical cell size required for passage through Start
Localization:
Intensity:
Fold change:
Significance:
-
C’ GFP library in SD
cytosol56.72 -
N' NOP1pr-GFP in SD
cytosol73.0295 -
N' TEF2pr-mCherry in SD

cytosol57.5058 -
N' NATIVEpr-GFP in SD
cytosol46.0958 -
N' TEF2pr-VC and Cyto-VN in SD
cytosol45.3089 -
C’ GFP library in SD+DTT

cytosolN/AN/ANo -
C’ GFP library in SD+H2O2

cytosol69.961.23No -
C’ GFP library in Starvation Media

cytosol53.360.94No -
C’ GFP library on the background of Pup2-DaMP

cytosol -
C’ GFP library on the background of CCT mutant

cytosol60.64021.06889No
